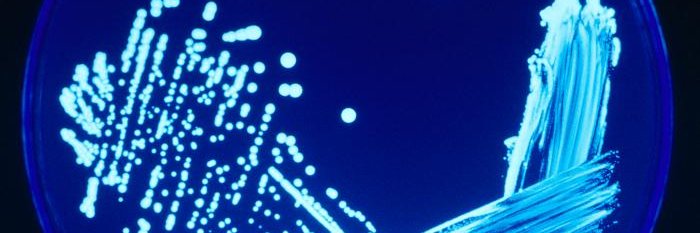
Pharmig banner

Sabitlenmiş Tweet

Sterility, Sterilisation and Sterility Assurance for Pharmaceuticals, this book comprehensively covers sterility, sterilisation and microorganisms, see: elsevier.com/books/sterilit…
English
Pharmig
26.6K posts

@PharmaMicro
Pharmig (Excellence in Microbiology) is the influential forum for microbiology in the pharmaceutical, healthcare and allied industries























Personally , I've now reached a point where I believe breaking the law for the climate is the ethically responsible thing to do . #ChrisPackhamC4 | @Channel4